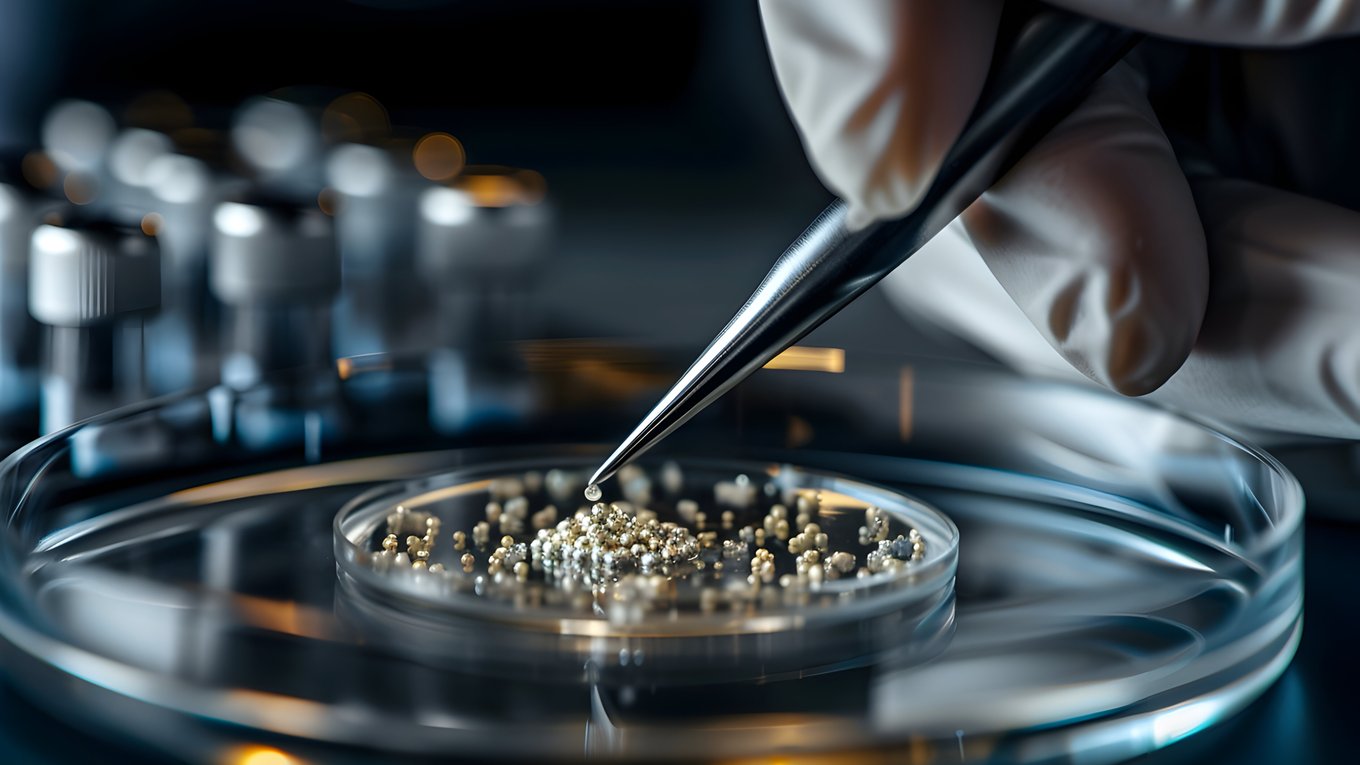
платина, катализатор, химия, производство, промышленность

Российские ученые разработали новый катализатор на основе платины с ультранизким содержанием частиц драгоценного металла (0,25%). Технология значительно упрощает и удешевляет производство α-кумилового спирта — соединения, используемого для создания полимеров, косметики и моющих средств.
Традиционные методы синтеза α-кумилового спирта требуют высоких температур (до +70°C) и давления (в 10–15 раз выше атмосферного), что усложняет процесс и увеличивает затраты. Более того, процесс достаточно опасный. Новый катализатор позволяет проводить реакцию при комнатной температуре и атмосферном давлении.
Использование платины в малых дозах (0,25%) также снижает стоимость производства по сравнению с катализаторами на основе палладия, которые требуют большего количества драгоценного металла.
Разработку представили ученые из Института органической химии им. Н. Д. Зелинского РАН и Института нефтехимического синтеза им. А. В. Топчиева РАН.